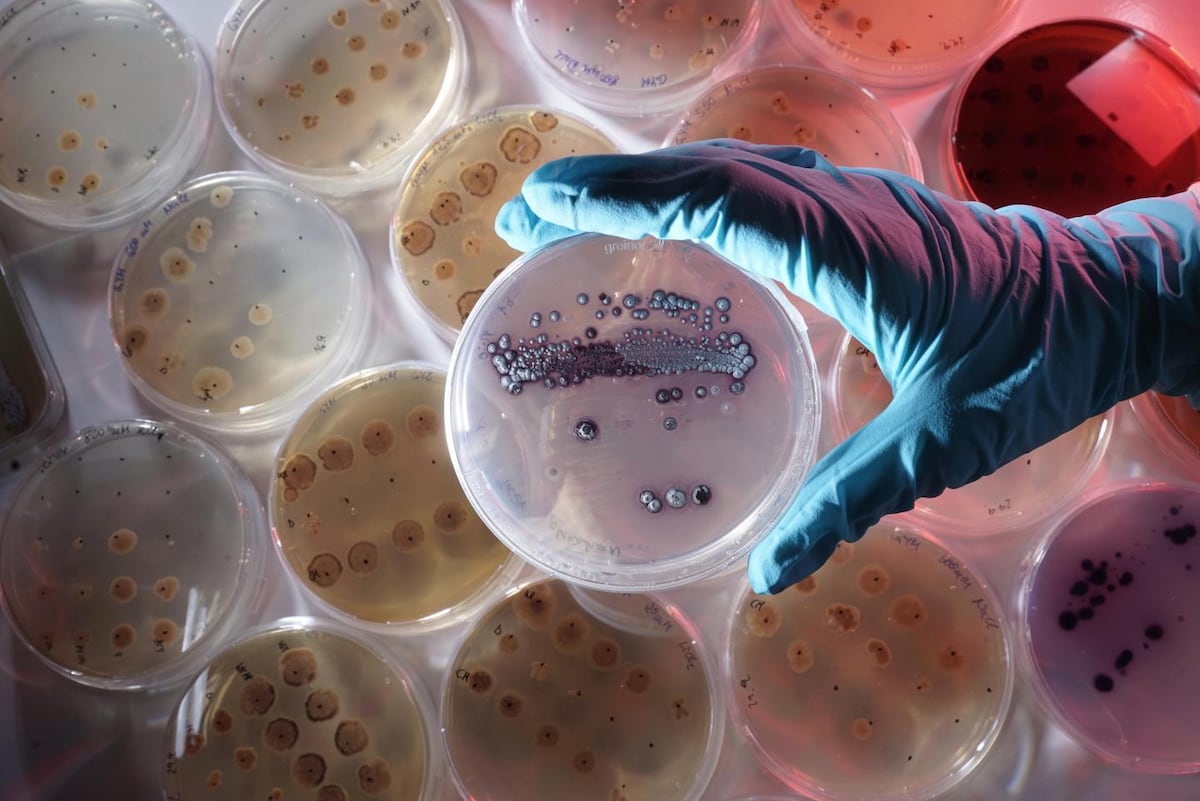
¡Descubren bacteria en la Estación Espacial China! Desafía todo lo conocido

En la Estación Espacial China Tiangong, los científicos del Grupo de Biotecnología Espacial de Shenzhou encontraron algo inesperado: una bacteria desconocida, bautizada Niallia tiangongensis, que resistía las duras condiciones del espacio. Las muestras fueron recogidas por la misión Shenzhou-15 y, al ser secuenciadas en la Tierra, revelaron que esta bacteria no aparece en ningún registro terrestre.
 Expertos evalúan el riesgo de que esta bacteria pueda afectar la salud humana, aunque por ahora no hay evidencia de peligro inmediato.
Expertos evalúan el riesgo de que esta bacteria pueda afectar la salud humana, aunque por ahora no hay evidencia de peligro inmediato.Lo sorprendente no es solo su origen desconocido, sino su capacidad para sobrevivir en un entorno sin nutrientes, microgravedad y radiación cósmica. Incluso crea “biofilms” que le permiten protegerse del vacío espacial. Aunque aún no se ha demostrado que sea peligrosa para los humanos, su pariente más cercano, Niallia circulans, puede causar infecciones en personas inmunocomprometidas.
Este descubrimiento abre la puerta a futuras aplicaciones en biotecnología espacial, desde reciclaje hasta construcción de hábitats extraterrestres.
Este descubrimiento abre la puerta a futuras aplicaciones en biotecnología espacial, desde reciclaje hasta construcción de hábitats extraterrestres.Este hallazgo abre nuevas puertas para la biotecnología espacial. Podría ayudar a diseñar sistemas de reciclaje en futuras misiones a Marte, generar oxígeno, o incluso construir hábitats autosuficientes en el espacio. Sin embargo, también recuerda lo vulnerable que podría ser nuestro planeta si organismos así se escapan de su confinamiento.



